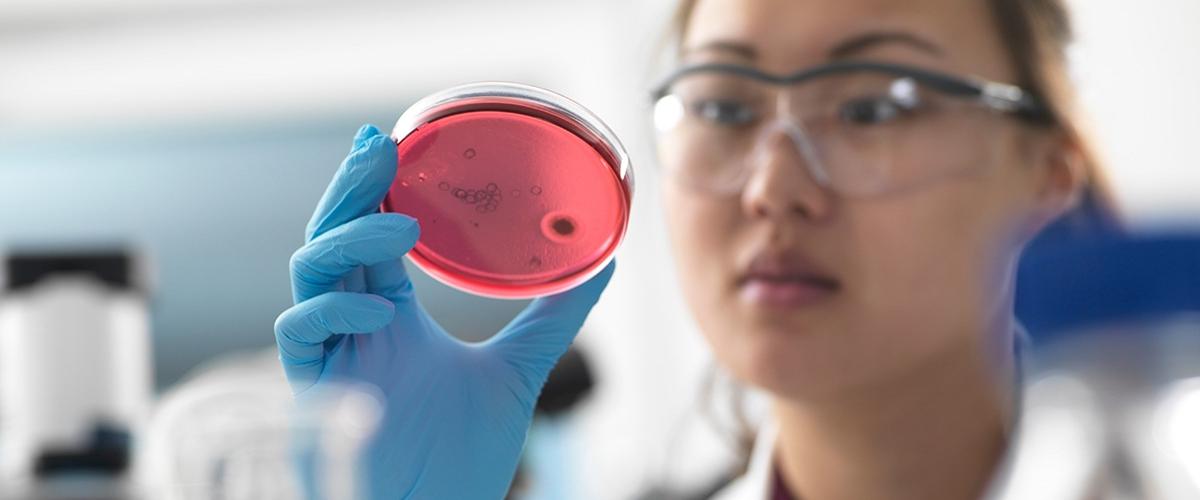
TODO:

Более 100 лет ученые знают, что одни люди метаболизируют холестерин в кишечнике намного эффективнее других. Также известно, что за этот процесс в кишечнике отвечают некоторые бактерии, благодаря которым холестерин преобразовывается в копростанол. Однако какие это бактерии и как именно они это делают, ученые до сих пор не знают.
Оказалось, что у людей с геном IsmA уровень копростанола в образцах стула был на 75% ниже, чем у пациентов без него, пишет New Atlas. Ген также коррелировал с более низкими показателями холестерина в образцах крови.
«Обнаружение этого гена указывает на наличие кишечных микробов, которые активно метаболизируют холестерин», — заявил соавтор исследования Рамник Ксавье.
Теперь ученые могут получить больше данных и сопоставить наличие и отсутствие потенциальных бактерий с уровнями холестерина у одних и тех же людей, чтобы определить ответственные за преобразование холестерина в копростанол бактерии.
«Теоретически мы видим, что бактерии кишечника могут снижать уровень холестерина у людей, однако пока у нас еще есть нерешенные вопросы», — прокомментировали авторы. Во-первых, нужно выяснить какие именно бактерии участвуют в процессе метаболизма холестерина. Во-вторых, важно понять, безопасно ли избыточное производство копростанола для здоровья человека.
Если гипотеза подтвердится, то это откроет новые стратегии для снижения уровня холестерина в организме человека, которые крайне необходимы для профилактики сердечно-сосудистых заболеваний. Сегодня основным препаратом для контроля холестерина являются статины, однако они обладают побочными эффектами.
Выводы данного исследования интересно коррелируют с результатами работы ученых из Дании. Они выяснили, что препараты для снижения холестерина снижают воспаление в кишечнике.